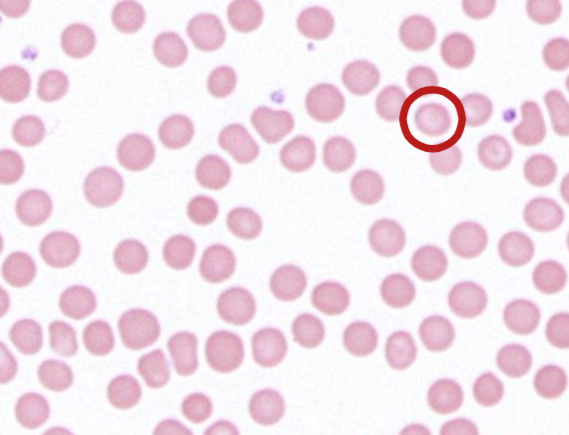
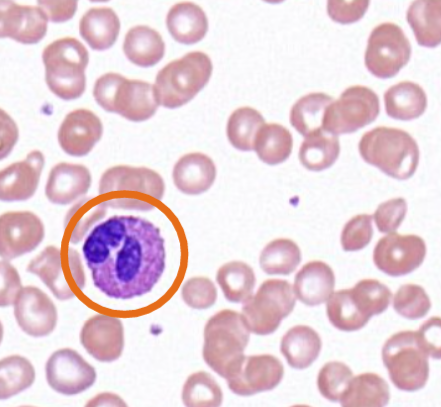
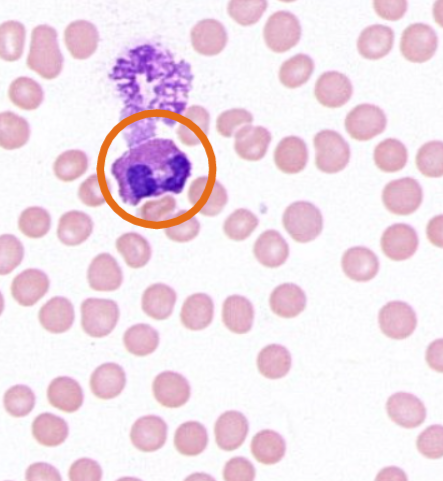
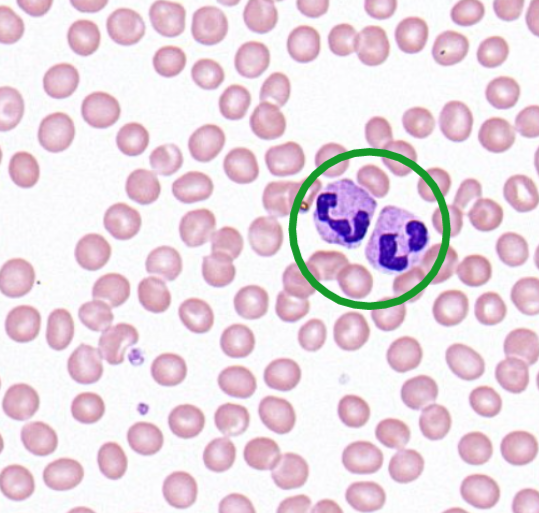
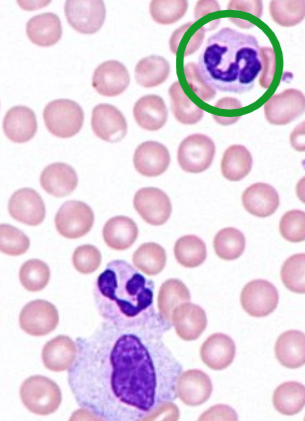
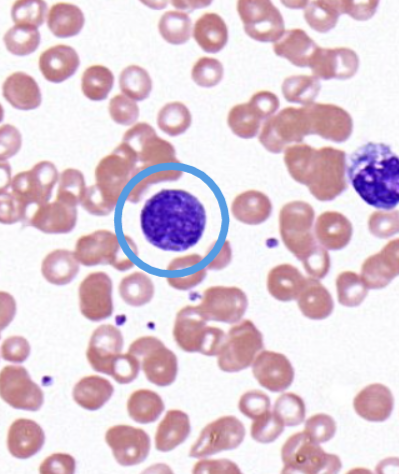
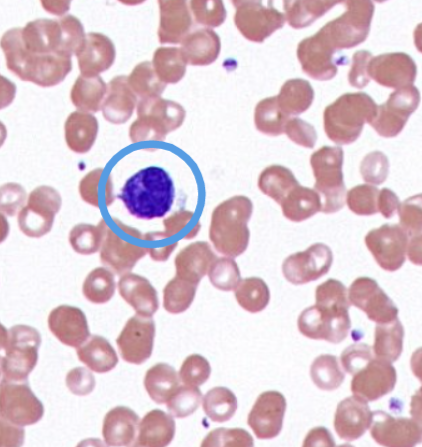
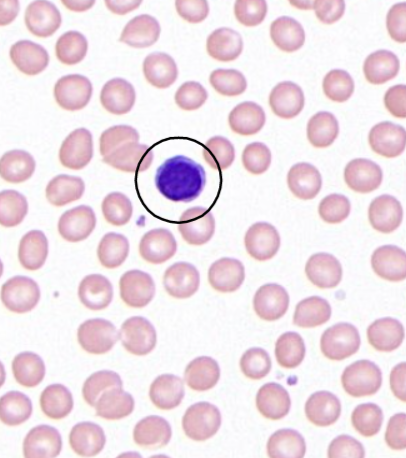
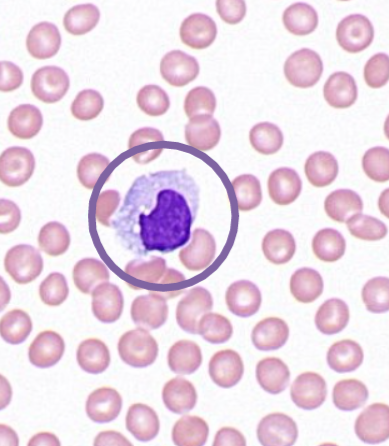
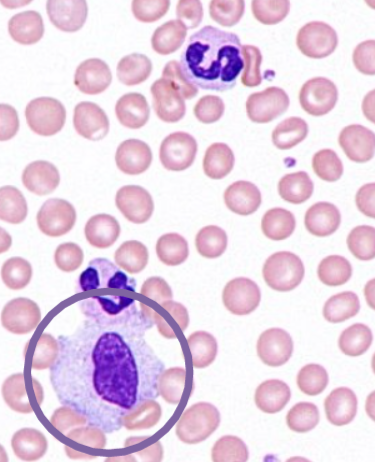
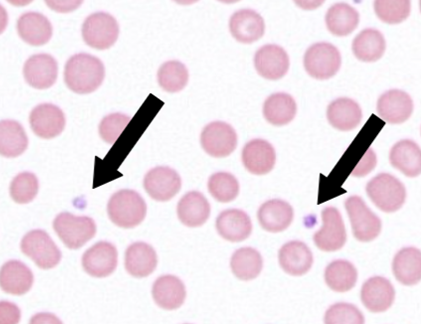
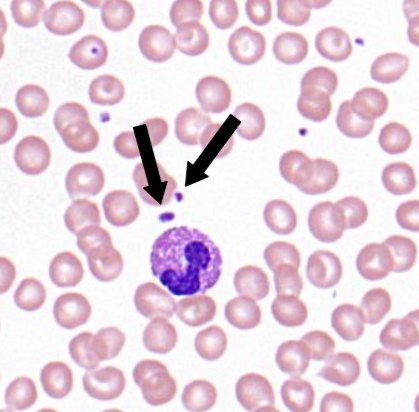

Bloedcellen
| Preparaat: | 101 |
| Species: | humaan |
| Kleuring: | Giemsa (May-Grünwald-Giemsa techniek) |
Dit preparaat is een uitstrijkje dat wordt gemaakt door een druppel bloed op een objectglaasje uit te strijken. De cellen worden aan de lucht gedroogd waardoor ze er groter gaan uitzien dan in suspensie gefixeerde cellen. Hun cytoplasma en kern kunnen zo beter bestudeerd worden.
Openen in volledig scherm
Op 40x vergroting zijn de volgende cellen te herkennen:
- Erytrocyten of rode bloedcellen (rode cirkel): Ronde tot ovale cellen zonder kern of organellen. In het midden zijn ze ingedeukt (lichtere kleur dan aan de celrand).

- Eosinofiele granulocyten (oranje cirkel): Deze cellen bevatten meestal twee kernlobben. In het cytoplasma bevinden zich veel grote, duidelijke granula die hier roodachtig tot oranje gekleurd en dus acidofiel of eosinofiel zijn.
- Neutrofiele granulocyten (groene cirkel): 2 tot 5 kernlobben met elkaar verbonden door fijne chromatinedraadjes (soms waarneembaar). Het cytoplasma bevat talrijke kleine granula (licht roze-violet gekleurd) die echter moeilijk te onderscheiden zijn.
- Basofiele granulocyten (blauwe cirkel): Deze cellen bevatten een minder sterk gelobde kern en talrijke grote purper gekleurde, dus basofiele, granula. De kern is moeilijk te onderscheiden door de aanwezigheid van de donkere granula.
- Lymfocyten (zwarte cirkel): De ronde tot boonvormige kern bevat zeer dicht opeengepakt chromatine en kleurt daarom zeer donker. Het cytoplasma vormt meestal slechts een smalle rand rond de kern.
- Monocyten (paarse cirkel): Monocyten bezitten een boonvormige tot hoefijzervormige kern die lichter gekleurd is dan de kern van de lymfocyten door het fijner verdeeld chromatine. De monocyt bevat ook wat meer cytoplasma dan de lymfocyt. Monocyten en lymfocyten kunnen vaak met elkaar verward worden. Beide celtypes kunnen verschillende vormen aannemen.
- Thrombocyten of bloedplaatjes (zwart pijltje): Ze kunnen hier teruggevonden worden als heldergekleurde paarse vlekjes.